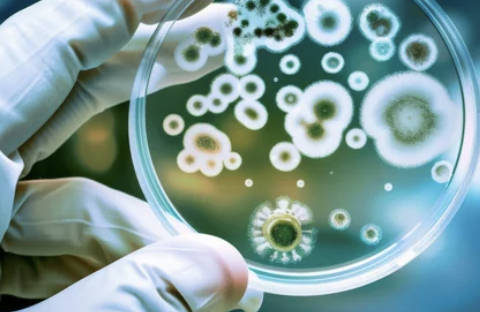

염증수치가 높은 이유 7가지
- 건강한 정보
- 2024. 9. 6. 21:07
🚨 몸속 빨간불! 염증 수치 높은 이유, 지금 바로 확인하세요! 🔥
1. 😷 잦은 감기, 혹시 면역력 저하 때문일까?: 만성 염증, 몸속 숨은 적!
최근 들어 감기에 자주 걸리고, 몸이 쉽게 피로해지는 것을 느꼈습니다. 병원을 찾아 혈액검사를 받아보니 염증 수치가 높다는 진단을 받았습니다. 의사 선생님께서는 만성 염증이 면역력 저하를 불러오고 각종 질병의 원인이 될 수 있다고 설명해주셨습니다. 염증은 우리 몸을 보호하는 중요한 역할을 하지만, 만성화되면 오히려 건강을 해칠 수 있다는 사실에 걱정이 앞섰습니다. 오늘은 염증 수치가 높아지는 원인과 관리 방법에 대해 자세히 알아보겠습니다.
2. 🍔🍟 기름진 음식, 혹시 내 몸에 독이 되고 있나요?: 잘못된 식습관, 염증 수치 높이는 주범!



- 가공식품과 인스턴트 식품: 가공식품과 인스턴트 식품에는 트랜스지방, 포화지방, 정제 탄수화물 등 염증을 유발하는 성분이 많이 함유되어 있습니다. 잦은 섭취는 만성 염증을 유발하고 면역력을 저하시킬 수 있습니다. 저도 평소에 패스트푸드나 인스턴트 식품을 즐겨 먹었는데, 염증 수치가 높다는 결과를 받고 나서 식습관을 개선하기 위해 노력하고 있습니다.
- 과도한 당 섭취: 설탕, 액상과당 등 단순당은 혈당을 급격히 올리고 염증 반응을 촉진할 수 있습니다. 단 음료나 과자, 빵 등 단 음식 섭취를 줄이고, 천연 당분이 함유된 과일이나 채소를 섭취하는 것이 좋습니다.
- 불균형한 오메가-3와 오메가-6 섭취: 오메가-3 지방산은 항염증 효과가 있는 반면, 오메가-6 지방산은 염증을 촉진할 수 있습니다. 따라서 오메가-3와 오메가-6 지방산의 균형 잡힌 섭취가 중요합니다. 등 푸른 생선, 견과류, 아마씨 등 오메가-3가 풍부한 음식을 챙겨 먹고, 옥수수유, 해바라기유 등 오메가-6가 많은 식용유 사용을 줄이는 것이 좋습니다.
3. 🤯 스트레스, 만병의 근원! 몸속 염증에도 영향을 미친다고요?: 스트레스, 염증 수치 높이는 주요 원인



- 스트레스와 염증의 관계: 스트레스는 코티솔 호르몬 분비를 증가시켜 면역 체계를 약화시키고 염증 반응을 촉진할 수 있습니다. 만성적인 스트레스는 만성 염증으로 이어져 심혈관 질환, 암, 자가면역 질환 등 다양한 질병의 위험을 높입니다. 저도 직장 생활과 육아 스트레스로 인해 늘 긴장하고 예민한 상태였는데, 이것이 염증 수치를 높이는 데 영향을 미쳤을 수 있다는 생각이 들었습니다.
- 스트레스 관리의 중요성: 스트레스를 효과적으로 관리하는 것은 염증 수치를 낮추고 건강을 유지하는 데 매우 중요합니다. 명상, 요가, 심호흡, 운동, 취미 활동 등 자신에게 맞는 스트레스 해소 방법을 찾아 꾸준히 실천하는 것이 좋습니다.
4. 🚭 담배, 술, 내 몸을 망치는 나쁜 습관: 흡연과 과음, 염증 수치 높이는 지름길



- 흡연: 흡연은 혈관을 손상시키고 염증을 유발하는 활성산소를 생성하여 염증 수치를 높입니다. 흡연은 폐암, 심혈관 질환 등 다양한 질병의 위험을 높이므로 반드시 금연해야 합니다.
- 과음: 과도한 알코올 섭취는 간에 부담을 주고 염증을 유발할 수 있습니다. 또한, 면역 체계를 약화시켜 감염 위험을 높이고 만성 염증으로 이어질 수 있습니다.
5. 🦠 혹시 몸속에 침입자가?: 세균 및 바이러스 감염, 급성 염증 유발

- 감염: 세균이나 바이러스 감염은 급성 염증을 유발할 수 있습니다. 감기, 독감, 폐렴 등 감염성 질환에 걸리면 염증 수치가 일시적으로 상승할 수 있습니다.
- 만성 감염: 만성적인 세균이나 바이러스 감염은 만성 염증으로 이어질 수 있습니다. 헬리코박터 파일로리균 감염, B형 간염, C형 간염 등 만성 감염 질환은 꾸준한 관리와 치료가 필요합니다.
6. 😴 잠이 보약! 수면 부족, 염증 수치 높인다: 충분한 수면, 건강한 면역 체계 유지에 필수



- 수면과 면역: 수면 부족은 면역 체계를 약화시키고 염증 반응을 증가시킬 수 있습니다. 충분한 수면은 면역 세포 활성화와 염증 조절에 중요한 역할을 합니다.
- 수면 시간: 성인은 하루 7~8시간 정도 충분한 수면을 취하는 것이 좋습니다.
- 수면 질: 잠자리에 들기 전 스마트폰 사용을 자제하고, 쾌적한 수면 환경을 조성하여 숙면을 취하는 것이 중요합니다.
7. 🏋️♀️ 운동, 염증 낮추는 특효약! 🏃♂️: 규칙적인 운동, 건강한 몸을 위한 필수 조건



- 운동과 염증: 규칙적인 운동은 혈액순환을 촉진하고 면역 체계를 강화하여 염증 수치를 낮추는 데 도움이 됩니다. 또한, 체중 감량에도 효과적이어서 비만으로 인한 염증 발생 위험을 줄일 수 있습니다.
- 적절한 운동: 유산소 운동과 근력 운동을 병행하는 것이 좋습니다. 자신의 체력 수준에 맞는 운동을 선택하고, 꾸준히 실천하는 것이 중요합니다.
참고 자료 및 추가 정보
- 질병관리청 국가건강정보포털: https://health.kdca.go.kr/
- 대한내과학회
마무리
염증 수치는 건강 상태를 나타내는 중요한 지표입니다. 염증 수치가 높다는 것은 몸 어딘가에 문제가 있다는 신호일 수 있으므로, 방치하지 말고 병원을 방문하여 정확한 진단과 치료를 받는 것이 중요합니다. 또한, 건강한 식습관, 규칙적인 운동, 스트레스 관리, 충분한 수면 등 생활 습관 개선을 통해 염증 수치를 낮추고 건강한 삶을 유지하시길 바랍니다. 😊
'건강한 정보' 카테고리의 다른 글
| 배에 가스가 자주 차는 이유 알아보기 (1) | 2024.09.27 |
|---|---|
| 부정맥 증상및원인 알아보기 ✅ (5) | 2024.09.22 |
| 등 통증이 의심되는병 총정리 🔥 (3) | 2024.09.06 |
| 난시 치료법 총정리 🔥 (2) | 2024.09.06 |
| 체했을때 먹으면 좋은 음식 7가지 (1) | 2024.08.31 |